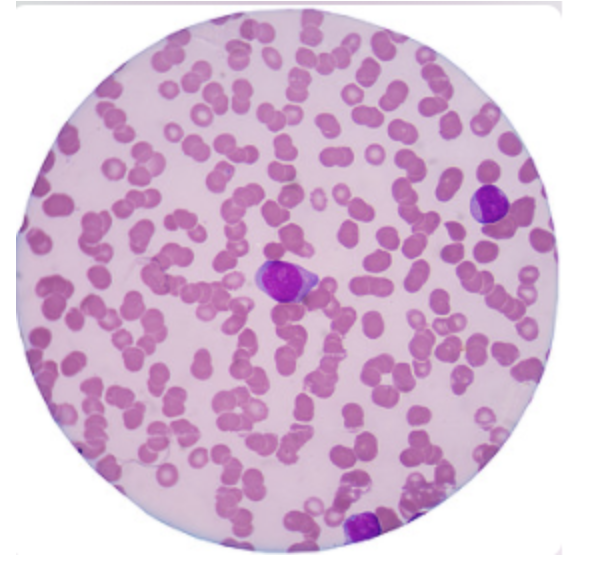

新闻动态
共 1 页/10 条记录
拯救生命药物的全球性紧缺——令人震惊的流行病
卢修斯随时准备满足您的需求
版权所有 © Copyright